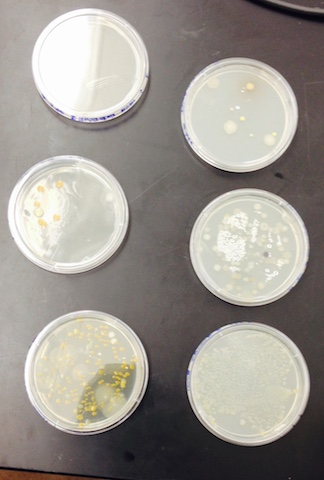

User:Brendan A Norwood-Pearson/Notebook/Biology 210 at AU
"Final Zebrafish Lab"
Introduction
In the past, there has been an array of tests and experiments run with animals and the effects of estrogen treatment. The diversity is widespread, from testing the effect of estrogen treatment on rice fish embryos (Uwa, 1976) to looking at the effect of estrogen treatment preventing female rats from having seizures (Rusa, 1999). Our lab sought to add to the Ethisterone research diversity by testing to effect of Ethisterone treatment with zebra fish embryos. Ethisterone is a progestin used for hormonal contraception, or an early form of the estrogen hormone that plays a role in birth methods (Uwa, 1976). While being a very important hormone for humans in general, Ethisterone is very important for successful pregnancies. Recent estrogen studies during human pregnancy claim that too much estrogen, and the embryos runs a risk of not being implanted, too little estrogen and the embryo risks not reaching the point of conception (Rodriguez , 2007). A more thorough understanding about Ethisterone levels during human pregnancy can only be obtained through testing within a characteristically eligible system. Zebra fish are known to be great systems for observation of embryo development for many reasons. One reason is that observations can be made so easily due to the translucence of the zebra fish (Herrmann, 1994). Being able to see the development from the inside as well as the outside of the animal proved to be advantageous. Another reason is because the zebra fish is an overall good system for chemicals that are able to pass placental barrier (Herrmann, 1994). Because of this, our findings can realistically compared to the hormone effects of a human embryo. One common characteristic of the animal Ethisterone studies reviewed by the lab is that an increase in growth, or rapid embryo maturation was recorded in treated embryos. This growth was accompanied by many different malformations of organs and bodily systems (Uwa, 1976). All of the studies reviewed by the lab seemed to focus on the physical state of the treated animals, but never the cognitive or behavioral. The goal of this experiment was to observe the stages of embryology within the treated zebra fish while paying attention to behavioral maturation. From observations made from a control and Ethisterone treated group of zebra fish over a span of two weeks, the lab found evidence that hinted toward a possible correlation between Ethisterone caused growth and behavioral maturation at the end of day seven.
"Methods and Materials" Since the lab was interested in the overall development and embryology of the zebra fish, the two-week period was planned out and different variables were recorded and noted at different days. With the exception of day zero and day one, recordings took place in three-day increments across a two-week experiment.
Day Zero
On day zero, the zebra fish for our experiment were chosen out of a bucket filled with eggs. The lab tried its best to find eggs that were translucent and healthy looking. Getting any dead or sickly eggs would undoubtedly throw of our results. In order to make sure there were no injuries to the eggs, a dropper was used in order to transfer the eggs from the bucket to the petri dish. In all, twenty eggs were obtained for our control group and twenty eggs were obtained for our test group. Each individual egg was viewed under a petri-dish microscope to confirm their health status and to record their stage of development. The stage of development was determined by the diagram on page 62 of the lab manual. Because of the vast number of eggs, an average stage of development was taken. Finally, twenty control group eggs were placed in a petri dish filled with 25mL of Deer Park water and twenty test group eggs were placed in a petri dish filled with 25mL of Ethisterone.
Day One On day one, the number of dead eggs, number of living embryos still within the egg, number of living larva, and the number of dead hatchlings were recorded. Repeating the same procedure from day zero. The petri dishes were carefully moved to petri dish microscopes in order to record accurate data. Day one recordings were very tricky because the eggs can seem to appear to be dead at first. We found that by gently pipetting liquid at the egg to gently shake it, one can tell if the larva are living or not by the reaction to the slight shaking of the egg.
Day 4 On day four, the petri dishes were cleaned up to ensure a healthy living space for the zebra fish. With a volumetric pipette, 10mLs of Deer Park water was taken from the control group and replenished 25mLs new water from the class stock. The same was done for the test Ethisterone group with new Ethisterone from the class stock. During this replenishing, any dead or moldy eggs were taken out and put in a waste bucket filled with paraformaldehyde. The number of dead eggs was recorded and any other excess waste accumulated in the petri dish was discarded.
Also on day four, pigmentation, eye movement, heart, pectoral fin, yolk sac size, swim bladder, development of the mouth, and general movement data were recorded for each group. All data was determined via observation under a petri dish microscope and the units measured were in ocular spaces into millimeters. The trick here was to try and find a sample that doesn’t move around too much. After day four, the number of dead zebra fish was recorded.
Day 7 On day seven, for both the test and control groups 5mLs of water or Ethisterone were extracted and replenished with 10mLs appropriately. Pigmentation, eye movement, heart, pectoral fin, yolk sac size, swim bladder, development of the mouth, and general movement data were recorded for each group via petri dish microscope. One healthy individual from both groups was taken and preserved in paraformaldehyde for future observation. The healthy individual was transferred via dropper, and placed into a test tube. One drop of tricane solution was added with the healthy individual in the test tube. During day seven we tested for behavioral differences in light sensibility and instinct. This was done by using the light under the petri-dish microscope as a light source, and by using a pipette tip as a way to test instinct. The petri dish was carefully moved over the light source and zebra fish behavior was noted. The pipette tip was gently stirred around the petri dish and zebra fish behavior was noted.
Day 11 On day eleven, the number of dead samples and live samples was recorded. Pigmentation, eye movement, heart, pectoral fin, yolk sac size, swim bladder, development of the mouth, and general movement data were recorded for each group via petri dish microscope. Each of the groups was given two drops via dropper of paramecium for food. Within the groups, 5mLs of their perspective liquids were extracted and replenished with 10mLs appropriately.
Day 14 On the final day of the experiment, final observations were made. Pigmentation, eye movement, heart, pectoral fin, yolk sac size, swim bladder, development of the mouth, and general movement data were recorded for each group via petri dish microscope. Each of the groups was given two drops via dropper of paramecium for food. Tail Measurements were made, the entire larvae were measured, and the diameter of the eyes was measured as well. All measurements were made via ocular spaces of the microscope and converted into millimeters.
"Results" Day Zero Results On day zero, the lab concluded that the majority of our zebra fish samples were in the 80% epiboly stage.
Day One results
Day one results are shown below. As you can see in Table A, the lab experienced some discouragement when we reported two deaths from our control dish and three from our tested group. The causal mechanism behind these deaths could not be determined in this early stage of development. The overall goal of day one was to start the experiment and to let our zebra fish embryos react to their environment. We also noted that the eyes were apparent after day one.

Day Four Results Below shows the results for day four of our experiment in table B. The live embryos all successfully hatched. No pigmentation for either group was visible. Eye movement was minimal in the control group but rapid in the tested group. It was minimal in the control group, but rapid in the tested group. The heart and heart rates were very difficult to tell at such an early age. The swim bladder and mouth development were minimal for both groups. As for the average size of the yolk sack, the tested yolk sacs were bigger than the control sacs by .1mm. [[Image:Bnpe.png]
Day Seven Results
Table C. shows the results from day seven. Growth was visibly obvious for both groups. The mouth and swim bladder development for both of the groups were more visible. Faster eye movement was recorded for the controls group. Notable movement with tails was observed in the tested group, and a heartbeat was found in the control but not in the tested zebra fish. During day seven we began the behavioral maturation tests of testing sensibility to light and instinct. As a result, it became increasingly aware that the tested group was more likely to respond to light sources and incoming pipette tips. The control group did not respond to the light groups at all, and some of them would have been hit by the pipette tip if the lab didn’t fear that we would have hurt them.

Day Fourteen Results
The results from day fourteen are shown in table D below. Upon day fourteen the experiment was coming to an end. By this time, the healthy individuals were isolated and stored. Information was collected for the final two zebra fish. Visually, the tested zebra fish looked very sickly and deformed. Not much data could be taken from it because it was in such bad shape. The control fish visually looked a lot better.
"Discussion" From the data and observations made throughout this experiment we can make some claims about the effect of Ethisterone on zebra fish eggs. The first major differences that were observed between the groups was the eye movement and the average size of the zebra fish. This was a really good start for the experiment because it fell in line with reports from the 1994 Herrmann study and certain aspects of the Uwa 1964 study. Development of eyes was mentioned to support a claim that zebra fish eggs grow fast (Herrmann 1994) and size difference was mentioned explicitly in the case of estrogen treated animals (Uwa 1964). Our results didn’t yield as much as a difference as some of the studies that we read, but we believe that to be because our experiment was so short. Another positive outcome is that deformity was the end result of the tested group within our experiment. As mentioned by the 1999 study by Rusa, physical deformities are major outcomes of excess levels of estrogen.
One interesting factor that was peculiar to the lab is that the heart, and pectoral fin seemed like they took a ling time to develop. After reading over a a study done by Charles B Kimmel entitled Stages of Embroyinc Development of Zebrafish, the lab found that this is actually normal in zebra fish development. Charles describes what he calls a “torpedo phase” that every healthy zebra fish goes through. During this phase, the pectoral fin can be absent. One unanswered factor that was noticed in our experiment was that we were not able to really see a heart beat in our tested group. As of now, we are accrediting this to experimental error.
Throughout the experiment, there were a lot of moments where our actions, or lack of actions, could have altered our data. One possible factor may be that there was a lot of liquid that spilled from the petri dishes during transfers of the dishes. This could have ultimately thrown off the concentrations of the environment of the zebra fish. We had no way of telling how much of the liquid fell out, so we replaced the liquid with a “ball park” volume. Another factor is that we were unable to come into the lab and look at our Zebra fish on day eleven. Day eleven is a crucial day in this experiment and we could have missed something big during that time. Also, the way that our petri dishes were stored wasn’t the best. Excess liquid from any petri dish stacked on top of ours could have leaked out and seeped into ours. This would ultimately throw off our results by having a variable not accounted for. Upon all of this, the lab’s method of testing behavioral maturation was not the best either. For an animal to have slow instincts and slow response to light does not necessarily mean that it is behaviorally immature. Because of all of these factors, the lab agrees that this experiment in particular would not hold the credibility of yielding information that might be helpful towards the study of estrogen levels within human pregnancy. In this experiment, the lab does not wish to make any outlandish claims that there is an absolute correlation between Ethisterone caused growth and behavioral maturation activity. What we have done is generally touched on an issue that will certainly require much more time and more accurate measures in order to come to a more developed claim. With this being said, as a lab we also do not wish to refute what we have found. Though the experiment was only for two weeks, potential correlation and possible trends toward the relationship between Ethisterone growth and behavioral maturation are likely.
"16s Sequence from Bacteria Lab- March 3 2015"
Purpose- The purpose of this experiment was for the lab to be able to take a closer look at the PCR products that we ran a while ago. The Gene that we amplified was the 16s gene from our bacteria that we grew from our transect samples. Looking at the products of the sanger sequencing and blasting them will ultimately enable the lab to identify the species of Bacteria and report on it.
Materials and Methods- The lab used raw sequences of our 16s gene per amplifications and put it into the BLAST system. Blast stands for Basic Local Alignment Search Tool. What it does is takes a sequence and matches it to an organism's genetic make-up as close as possible. By simply entering the data that was collected from sanger sequencing into the BLAST data base, the lab was able to identify our bacteria species.
Results- Listed Below is the raw sequence of our sample.
MB 35: Chryseobacterium NNNNNNNNNNNNNGCTNNGCAGCCGAGCGGTAGAGATTCTTCGGAATCTTGAGAGCGGCGTACGGGTGCGGAACACGTGT GCAACCTGCCTTTATCAGGGGGATAGCCTTTCGAAAGGAAGATTAATACCCCATAATATATTAAGTGGCATCACTTGATA TTGAAAACTCCGGTGGATAAAGATGGGCACGCGCAAGATTAGATAGTTGGTAGGGTAACGGCCTACCAAGTCAGTGATCT TTAGGGGGCCTGAGAGGGTGATCCCCCACACTGGTACTGAGACACGGACCAGACTCCTACGGGAGGCAGCAGTGAGGAAT ATTGGACAATGGGTGAGAGCCTGATCCAGCCATCCCGCGTGAAGGATGACGGCCCTATGGGTTGTAAACTTCTTTTGTAT AGGGATAAACCTTTCCACGTGTGGAAAGCTGAAGGTACTATACGAATAAGCACCGGCTAACTCCGTGCCAGCAGCCGCGG TAATACGGAGGGTGCAAGCGTTATCCGGATTTATTGGGTTTAAAGGGTCCGTAGGCGGATCTGTAAGTCAGTGGTGAAAT CTCACAGCTTAACTGTGAAACTGCCATTGATACTGCAGGTCTTGAGTAAGGTAGAAGTAGCTGGAATAAGTANTGTAGCG GTGAAATGCATANATATTACNTANNNNACCAATTGCGAAGGCAGGTTACTATGTCTTAACTGACNCTGATGGACNAAAGC GTGGGGAGCGAACAGGATTNNATACCCTGGTAGTCCACNCCGTAAACGATGCTAACTCGTTTTTGGGNCTTCGGATTCNN ANACTAANCGAAAGTGATAAGTTAGCCNACCTGGGAGTACNGTTNNNNAGAATGAAACTNNNANNANNNACGGGGGCCNN NNNNACCGGNNNNTATNTGGTTTNAGTGCNATGATNCGCGAGNANCNNTACCACGCNTNAANTGGGGAAGTGAGGNNGGT TNGNNNGNNNNCGTNNNTNCNNCAANTTTCAANNNNNTCCNGGGTGNNGGNGGGNNGTNNNNNANNGNTANGTNTAGGTN CNNNGACNAGCNCNNCCCCCNNNNNCGGGNNNGGGCGGNTNNNTTNCNGGANNNCNNNNNGNGNNNCCCTTGNNNNN
MB 36: Variovarax NNNNNNNNNNNNNNNNNTNNNNTGCAGTCGTANGGNGGTCAGCGCGTANCAATCCTGGCGGCGAGTGGCGAACGGGTGAG TAATACATCGGAACGTGCCCAATCGTGGGGGATAACGCAGCGAAAGCTGTGCTAATACCGCATACGATCTACGGATGAAA GCAGGGGATCGCAAGACCTTGCGCGAATGGAGCGGCCGATGGCAGATTAGGTAGTTGGTGAGGTAAAGGCTCACCAAGCC TTCGATCTGTAGCTGGTCTGAGAGGACGACCAGCCACACTGGGACTGAGACACGGCCCAGACTCCTACGGGAGGCAGCAG TGGGGAATTTTGGACAATGGGCGAAAGCCTGATCCAGCCATGCCGCGTGCAGGATGAAGGCCTTCGGGTTGTAAACTGCT TTTGTACGGAACGAAACGGCCTTTTCTAATAAAGAGGGCTAATGACGGTACCGTAAGAATAAGCACCGGCTAACTACGTG CCAGCAGCCGCGGTAATACGTAGGGTGCAAGCGTTAATCGGAATTACTGGGCGTAAAGCGTGCGCAGGCGGTTATGTAAG ACAGTTGTGAAATCCCCGGGCTCAACCTGGGAACTGCATCTGTGACTGCATAGCTAGAGTACGGTAGAGGGGGATGGGAA TTCCGCGTGTAGCAGTGAAATGCGTAGATATGCGGAGGAACACCGATGGCGAAGGCAATCCCCTGGACCTGTACTGACGC TCATGCACGAAANNNGTGGGGAGCAAACAGGATTANATACCCTGGTAGTCCACGCCCTAAACGATGTCNACTGGTTGTTG GGTCTTCACTGACTCANTAACNAANCTAACNCGTGAAGTTGACCGCCTGGGGANTACGGCCGCAAGGTTGNAAACTCANN GAATTGANNGGGNNCCNCACAANCNGTGGATGATGTGGTTTATTTNNTNNCAACGCNAAAACCTTACCCACCTTTNGACA TNTACGGAATTCGCCNGANATGGNTTANTGCTCGANAGNANAANCNNTACANCNNGTGCTGCATGGCTGTNNTCNNCTCG TGTNNNTGNNANNNTGGNTNANNCCCNCAACNNNCGCAACCCNNNNTCATTNNNTGGCTACNTTCGNNTNGGCNNTCTNN GGNNACTGCCNGNTGANNNAC
The species identified as Variovarax and Chryseobacterium.
Shown above is a picture of the gel that was originally run. Indicated by the red circle is the two gene samples that were sent in for sanger sequencing.
Results -
The Variovarax genus is a family of bacteria that can be found in soil. From this, the lab concluded that this type of bacteria came from our ground litter sample that we extracted from our transect. Bacteria in this genus have been long known to break down boron, a toxic element that can be harmful to certain aspects of ecosystems similar to that of our transect.
The Chryseobacterium bacteria is a member of a family of bacteria that is closely linked to meningitis. This bacteria has no mention of being able to directly benefit the type of ecosystem that we collected our data from, but it is actually very cool to see the diversity of such bacteria in a small place like a transect at AU.
Work Cited
Jacobs, R., KC Bloch, and R. Nadarajah. "Chryseobacterium Meningosepticum: An Emerging Pathogen among Immunocompromised Adults. Report of 6 Cases and Literature Review." NCBI (1997): n. pag. Pubmed.com. Web. 2 Mar. 2015.
H. Miwa - I. Ahmed - J. Yoon - A. Yokota - T. Fujiwara - International Journal Of Systematic And Evolutionary Microbiology - 2008
Zebra Fish Experiment- Feburary 25 2015
For the zebra fish experiment my partner is Roshni. We both decided to use the Estrogen as our independent variable. We hypothesize that the presence of estrogen will cause the zebra fish to grow at a faster rate. More specifically, their body mass will be disproportional to their organ mass in comparison to the control zebra fish. So far we have growing zebra fish in our petri dishes. One control and one test. The test is filled with 25mL of estrogen and the control is filled with 25mL of control water. We will record their size and average them out along the course of a couple of weeks. This is cool.
BNP
2.24.15
Good Invertebrate entry. Missing the vertebrate section with description of vertebrates present in transect (or potentially present) and a food web.
SK
" Invertebrates-Feburary 18 2015"
Purpose The purpose of this lab was to look at the different invertebrates collected from our Berlese Funnel and to look at other invertebrates in order to experience the diversity of the invertebrate family first hand. The lab recorded the phylum, size, quantity of the invertebrates within the petri dish, and a description for each of the different invertebrates that we observed.
Methods and Materials The invertebrates were collected out of the ethanol that they fell into in our Berlese Funnel and put into a clear petri dish for viewing via microscope. The results were nothing short of overwhelming as many different type of invertebrates were discovered. A centipede, a small sole mite, a spring tail, and a large soil mite were all found in our transect.
Results
Above is the data that was collected.A centipede, a small sole mite, a spring tail, and a large soil mite were all found in our transect. They ranged from .2 to 1mm in size. The lab recorded the phylum, size, quantity of the invertebrates within the petri dish, and a description for each of the different invertebrates that we observed.
Above is the centipede that was observed by the lab. It was identified by the number of legs and unique appearance. This was a very exciting find for the lab.
Discussion
Additionally, an acoelomat, a planaria, and a nematode were observed. The acoleomat was observed as moving with its whole body. It seemed as if the worm used a lot of energy to go a short distance. The planaria was observed to move more like a snake, very slow and decisively. The nematode was seen to slither.
The invertebrates observed have been shown to participate in many different aspects of ecology. For example the centipede is crucial to the ecosystem by being a predator pushing natural selection, and soil mites have been shown to break down dead leaves and release the nutrients back into the soil. In all, the invertebrates observed are shown to carry their weight in the ecology system.
Conclusion and Future Directions In conclusion the invertebrates that the lab observed showed to effect both biotic and abiotic aspects of our transects. Next week we will begin our trials with zebra fish!
BNP
2.19.15 Good lab book entry. Focus should be on the plant part of the lab as the PCR part will be more relevant when get sequence data back. SK
"PCR for 16s along with Plantae and Fungi-Febuary 11 2015 "
"Purpose" The purpose of this experiment was to put the PCR product that accumulated in last week's lab and run it through a gel. We also returned back to our transect spot, where we collected samples for our Hay Infusion Culture, and picked leaves off of trees and bushes. We then used our knowledge obtained in class and in the lab manual to jot down various characteristics about the leaves like vascularization and mechanism of reproduction, just to name a few. Finally, we needed samples from our transect in order to set up a Berlese Funnel to Collect Invertebrates.
"Materials and Methods" We used the PCR product from last lab, combined 5 micro liters of our sample with 3 micro liters of dye, and pipetted it into a gel electrophoresis well. After running the gel, we recorded the data. The lab visited our transect sight and got samples of ground material and 5 samples of leaves. We observed the leaves and put in ground material in an inverted funnel with a filter known as a Berlese Funnel.
Data and Observations
Above is a picture of the PCR gel that we ran to amplify the 16s Gene. As you can see, in the first well (from left to right) we added a ladder to measure the base pairs of the gene, and each PCR product was put in a well.
 Above are the data for the five leaves that we collected. Characteristics include size, vascularization, location, specialized structures, and Mechanisms of Reproduction. We found our leaves on trees and pushes, some of them were dead and had fallen off. As it turns out, just like humans have vascularization, leaves have vascularization too. We found xylem and phloem under the belly of our leaves which indicated that they all had vascularization. We also saw cuticles, a layer of waxy substance, on the outer edge of our leaves too.
---Leaf 1 came from a low hanging plant in a loose cluster of other leaves
---Leaf 2 came from a bush with dense leaf clusters
---Leaf 3 came from the ground
---Leaf 4 came from a tall tree with dense leaf clusters
---Leaf 5 came from a small bush with a loose leaf cluster
Above are the data for the five leaves that we collected. Characteristics include size, vascularization, location, specialized structures, and Mechanisms of Reproduction. We found our leaves on trees and pushes, some of them were dead and had fallen off. As it turns out, just like humans have vascularization, leaves have vascularization too. We found xylem and phloem under the belly of our leaves which indicated that they all had vascularization. We also saw cuticles, a layer of waxy substance, on the outer edge of our leaves too.
---Leaf 1 came from a low hanging plant in a loose cluster of other leaves
---Leaf 2 came from a bush with dense leaf clusters
---Leaf 3 came from the ground
---Leaf 4 came from a tall tree with dense leaf clusters
---Leaf 5 came from a small bush with a loose leaf cluster
No fungi were found in our transect. Fungi sporangia are important because they produce haploid spores or "seeds" that give fungi the ability to grow in other places.
Above is a picture of the Berlese Funnel, I assume that we are going to be using it in order to examine Invertebrates in the near future.
2.10.15 Very good entry. Could include serial dilution data table in results section. Address all red text in manual. Also give some detail about the gram stain protocol or include a link to a comparable protocol. SK
Microbiology and Identifying Bacteria with DNA Sequences- January 29 2015
Purpose To build off of the knowledge obtained from last lab section by observing the different characteristics of bacteria, experience the reality of antibiotic resistance, and to use DNA sequences in order to identify different species of bacteria.
Materials and Methods The lab looked at each of the petri dishes containing the bacteria from the Hay Infusion Culture and recorded evidence of antibiotic resistance. In order to observe the bacteria that we grew last lab section, we extracted samples from each petri dish, made a wet mount, and looked at it through the microscope. We then stained the bacteria we observed in order to determine weather the bacteria were gram negative or positive. Finally, we isolated DNA from the bacteria and amplified the 16S rNA gene via PCR for our next lab.
Data and Observations First off, our Hay Infusion Culture had a lot less water inside of it. More than likely due to evaporation. It smelled a lot worse in comparison to the last time we took samples from it. There was also mold present within it. We observed that the platelets with the tetracycline antibiotic yielded less bacteria colonies than the ones without it. This was expected due to the fact that tetracycline is known to prohibit the bacteria polymerase from continuing transcription. However, we also found that a purple colored colony seemed to be persistent throughout all of the dishes suggesting that it may have a resistance to the tetracycline antibiotic.
 This is a Gram Negative Spirillum that we found within our Hay Infusion Culture. Its pinkish color indicates that it does not have an outer layer made of peptidoglycan (x100 magnification)
This is a Gram Negative Spirillum that we found within our Hay Infusion Culture. Its pinkish color indicates that it does not have an outer layer made of peptidoglycan (x100 magnification)
This is a picture of the bacteria colonies that we collected samples from and observed the antibiotic resistance.
This is a picture of the bacteria colonies that we collected samples from and observed the antibiotic resistance.

For the PCR reaction we used two samples from the 10x7 Tet colony and two samples from the 10x9 Tet colony.
Conclusions and Future Directions In conclusion, we observed evidence of the Tetracycline antibiotic working as an antibiotic to some colonies, and we also witnessed resistance against it. Through our observations via microscope we were able to identify different characteristics and types of bacteria in our Hayford Infusion Culture and determine weather they were gram negative or positive via staining. When we return to the lab, we will use the amplified 16S gene and put it through a gel. Once the samples from the Gel or sequenced, we will use them to identify bacteria.
BNP
2.4.15 Good notebook entry. Picture is too big. Try saving it as a smaller file size and then uploading it. SK
Hay Infusion Culture Observations and Preparing and Plating Serial Dilutions- January 22 2015
Purpose In order to apply the knowledge learned last week to this week, examination of samples from our previously prepared Hay Infusion Cultures is necessary. The lab has reasons to believe that there are unicellular Eukaryotic organisms within our sample and we will identify them. Plating serial dilutions need to be done in order to prepare for next week's lab.
Materials and Methods A sample of the Hay Infusion Culture was taken and observed through a microscope and many different types of organisms were found within the sample. A Dichotomous key was used in order to identify different organisms and the characteristics that they embody. A wet mount of known organisms were observed first in order to familiarize ourselves with some of the unicellular organisms that we could see in our sample. The results were recorded. For the serial dilutions, 10 uL of the Hay infusion sample was taken and put through a three series 100 ul dilution with sterile broth. From those dilutions, 100 ul of each of the tubes within the dilution series was transferred into nutrient agar plates. A separate 100 ul of original dilution series was put into a nutrient agar plus tetracycline plate. This was done so that bacteria colonies would grow. The details of this dilution are depicted below.

Data and Observations Different organisms were living at different levels of our Hay infusion Culture so the lab took samples from the top, the middle, and the bottom. At the top we found Chlamydomnas (10 micrometers), Clopidiunm (50 micrometers), and Paramecium (90 micrometers). At the bottom of the sample we found Peranama (50 micrometers), Chalmydonas (7 micrometers), and Paramecium Caudatum (230 micrometers). In the middle Paramecium bursaria (90 micrometers) were found. One organism that caught the interest of the lab was the Chlamydomnas and its intense flagella that enabled the organism to be very fast and motile. It was difficult to identify the organism because of its speed. Luckily, we caught it as it was taking a breather.
Conclusions and Future Directions From this lab, we can conclude that the diversity of organisms within our transect is very colorful in regards to types of organisms. If our sample were to grow for another two months, we would probably observe a lot more kids of organisms present. We would need a lot of proteasome!
Observation of Volvocine Line and Observing a Niche at Au- January 15th 2015
Purpose: To examine organism diversity as a product of evolution first hand by looking at the Volvocine Line algae group through the microscope. Then, venture out into the natural habitat of these organisms by taking samples of soil from our assigned 20x20 transect. From our samples, we will differentiate between abiotic and biotic components within our niche and create a Hay Infusion Culture for future projects.
Materials and Methods: As a class, we used Microscopes and hand prepared slides in order to look at the organisms of interest. They were Chlamydomas, Gonium, and Volvox collectively. After recording the number of cells, colony size, specialization, mechanisms of motility, and the status of their gametes we were able to get a sense of the diversity of just one type of organism. With this in mind, the lab journeyed out to our assigned transect and collected aspects of our transects and put it in a tube. This tube was later emptied into a jar along with some milk and water, and saved on a shelf.
This is a sketch of the transect that the sample for the Hay Infusion was taken from. It was a very lush corner of our campus with lots of plants and bushes. Abiotic components consisting of dirt, rocks, snow, a lamp post, and metal signs. Biotic components consisting of trees, ants, bushes, micro organisms, birds.
This is the collected data from the Volvocine Line.
Conclusion and Future Directions: We can conclude that evolution has indeed made our world diverse in the organism realm. In the future, we will look at the Hay infusion Culture and collect samples from it.
BNP






